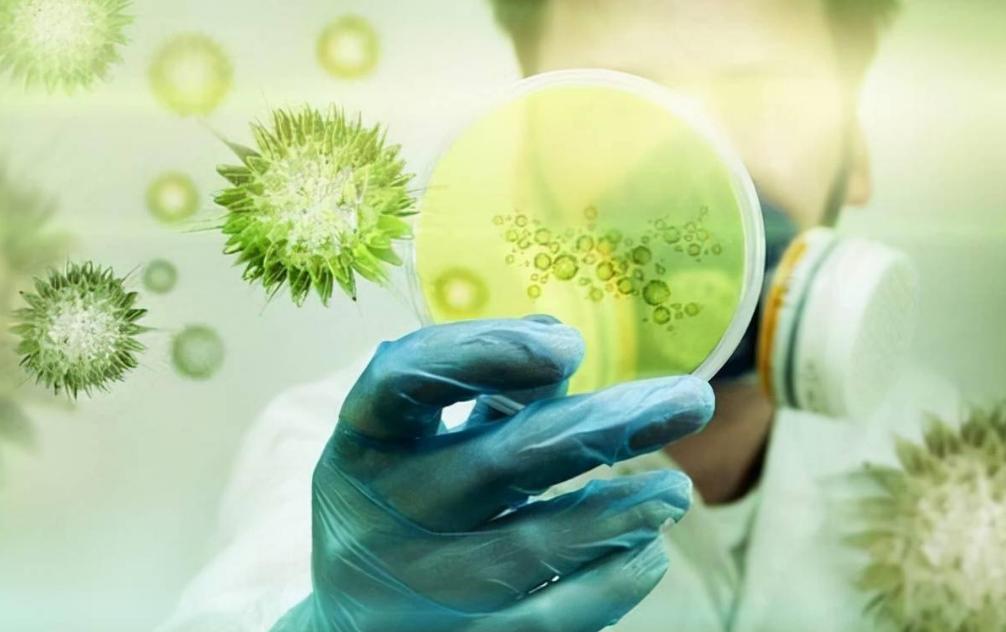
头皮总是长疙瘩或脓包是什么原因,头皮反复长疖肿起脓包

想必很多人都有过这样的体验,洗头或者梳头的时候无意中触碰到头皮上的“小火山”,紧接着那一瞬间爆发的疼痛感可谓是痛彻心扉,而这个“小火山”其实是头皮上的痘痘。那么问题就来了,脸上长痘痘很常见,头皮怎么也会长痘呢?和脸上的痘痘一样吗?
头皮有“痘”,小心4种疾病在搞怪
日常生活中,很多人尤其是女性很关注自己面部的护理。但实际上身体皮肤的护理不仅仅是脸部、颈部、手部和四肢,还有一个非常重要的部位很容易被忽视,那就是头皮。

头皮就是覆盖在头部的皮肤,其构成含有极为密集的毛囊、皮脂腺以及汗腺结构,且头皮的生态环境非常复杂。一个健康的头皮需要同时满足皮脂、代谢和菌群三者的平衡。
只要其中一项的平衡被打破,就会出现油腻、头痒、头皮脓包、头皮屑等表现。
前往皮肤科就诊的很多患者通常是频繁出现头皮脓包,过度瘙痒,自行用药后有所缓解,但是好景不长又再复发。发生这种头皮疙瘩或脓包时,建议考虑是不是出现了下面的这些疾病。

最常见、最先被考虑的疾病多是头皮毛囊炎。头皮毛囊炎,属于以头部毛囊受累为主的炎症性皮肤疾病,日常很常见并且高发,尤其是在夏天常见。毛囊炎的发生通常在毛发旺盛的部位,例如头部。令人头疼的是,毛囊炎不仅高发,而且易复发,较为难治愈。
导致毛囊炎发生的原因,多数是葡萄球菌感染。一旦发生长期头皮清洁不利、身体抵抗力下降等情况,便在头皮毛囊口出现红色丘疹,然后在短时间内迅速发展为脓包,出现瘙痒或疼痛感,甚至会伴随脓液的挤出。
其次,导致头皮长疙瘩或脓包的疾病还可考虑脂溢性皮炎。脂溢性皮炎,指在皮脂溢出部位广泛发生的慢性皮肤炎症,而头皮因含有丰富的皮脂腺就成了该疾病的高发部位。究其原因,马拉色菌的“参与”不容忽视。

一旦忽略头部卫生,长期不洗头,就会导致头皮油脂大量聚集,因此马拉色菌会在头皮毛囊中大量繁殖,进而破坏头皮的角质细胞。
轻者头发油腻并出现灰白色小片糠状或鳞状皮屑,头皮现红斑且有瘙痒感;严重者头皮会出现大片油腻性疙瘩或厚痂,或有渗液,因瘙痒难耐而剧烈搔抓后易导致头皮感染发生。
头皮生出疙瘩或脓包的疾病还有粟粒性坏死性*疮痤**。
有的人可能会疑惑*疮痤**不都是长在脸上的吗?而粟粒性坏死性*疮痤**却是仅发生在头皮,尤其好发于头顶和枕部。该病一旦发生就会在毛囊口形成小水疱,然后迅速转化为粟粒大小的脓包。

虽然它的发病原因和毛囊炎一样,也是葡萄球菌感染所致,但是其病程迁延可是比毛囊炎久多了。
最后要说到一个最严重的疾病,那就是头皮鳞状细胞癌。该疾病通常起源于表皮或皮脂腺导管、毛囊、汗腺等部位的角阮细胞。头皮上出现小疙瘩或脓包往往属于原发性鳞癌,早期可见小型丘疹或者疣状突起,表面较为粗糙但生长很迅速。
该疾病发生的原因多是日光、放射线照射,化学物质刺激,慢性溃疡或者深部真菌感染等。
接下来我们还要了解哪些人会被头皮问题经常“偏爱”呢?
头皮经常出问题,被“偏爱”的人群都有哪些特点?
细数头皮经常出现问题的人群,大概有下面这样的共性。
首先就是不注意个人卫生。这类人群一般是很长时间才洗一次头,或者是洗头的时候没有完全洗干净。加上如果工作环境中遍布粉尘等有害物质的话,长期“寄居”在头皮的话会堵塞头皮毛孔,容易引发细菌或真菌的大量繁殖,进而导致头皮问题出现。
其次就是经常出汗的年轻人。这类年轻人身体新陈代谢都比较快,日常的运动量也很大,因此身体皮肤尤其是头部,经常处于潮湿、油腻的状态之下,而细菌和真菌则就喜欢这样的环境,加之忽视了卫生清洁,便会常常出现头皮问题。

身体的免疫力是对抗一切疾病的法宝,免疫力低的人群很多疾病都会找上门来,头皮问题也在其中。免疫力低下、体质差都很容易受到细菌或真菌的侵袭,因此出现的感染便会诱发头皮问题。
另外,即便是清洗了头发,但是使用洗发水、护发素的时候没有冲洗干净也会导致头皮长痘。不冲洗干净就会造成洗发水或护发素粘附在头皮或头发上,碰上空气中的灰尘等物质就会堵塞毛囊,引起头皮问题。
头皮的不健康问题我们有了了解后,就要考虑加强营养护理了。但生活中很多人对于头发护理往往还存在误区。

养发护发别进误区,正确保养头发才能健康
回想一下,是不是很多人在发现自己的头发出现分叉后,认为直接剪掉就行了。其实这就属于护发的一个误区。
头发出现的分叉并不是一剪了之,如何防止头发继续分叉才是根本。
需要及时摄取维生素和蛋白质,加上使用富含营养成分的护发产品定期保养头发,才可以维持头发的健康,预防再度分叉。
还有的人在洗了头之后立马就用吹风机吹干,这也是一个错误行为。
洗发之后立即用吹风机,会造成头发受损、干燥甚至开叉。正确的做法应该是先用相对宽齿的发梳梳通湿发,等到半干的时候在用吹风机吹干。另外吹风机的选择也不是功率越高越好,建议500-700瓦的吹风机就可以了,既可以吹干又不会伤害头发。

那么正确保养头发还有哪些注意事项呢?
首先要明确头发的护理和保养也都是要讲究科学性,不同的季节也会有不同的护理方法。
春天的时候万物复苏,也是有利于头发生长的季节,但是春天很多时候会刮风,也会下雨,所以在这种时而干燥时而潮湿的季节里,保持头发水分平衡是非常重要的。建议可以选择具有保湿功效的洗发水,梳头发的时候最好将头发分散开,有助于头皮的通风。
夏天的骄阳对于头发的伤害还是很大的,因此更需要尽心呵护头发。夏季的高温和烈日都会加快身体的新陈代谢,进而皮脂腺会分泌出大量的油脂。同时人体的多汗也会增加头发水分,所以夏季护发注重防晒和适当用护发素就好了。

建议夏季出门要注意佩戴太阳帽或者打遮阳伞做好头发防晒。另外使用护发素的时候不用过于频繁,1周用1次就可以了,油性发质的话只用在发尾就可以了。
秋季空气干燥,头发更易断裂脱落,所以秋季应该增加细润效果好的洗发水和护法素保养头发。而冬季的天气寒冷,头发更易干燥或发生静电,所以头发的保湿和润泽就是关键。建议可以适当提高室内湿度,增加护发素的使用次数,加上经常按摩头皮,都能起到润泽头发的作用。
其次就是头部卫生的注意。平时养成勤洗头的好习惯,洗头发的时候最好用温水,保持头发和头皮的清洁和干爽。同时自己的毛巾或者枕巾等要做好定期的清洗和更换,毛巾不与他人混用,枕巾最好每周更换清洗1次。

平时最好保持清淡饮食,建议多吃新鲜的蔬菜水果,避免油腻、煎炸、辛辣刺激等食物,避免造成头皮油脂过度分泌,引发毛孔堵塞。
延伸阅读:斑秃,迎来新药!恢复约80%以上头发生长
斑秃,相比很多人都听说过,斑秃发生后可见头皮突然出现边界清晰的圆形斑状脱发,大部分患者可以自愈,但是其中又有一半的患者会反复发作长达数年甚至数十年。
平时治疗也是多以激素为主,但是副作用很多。寻找有效药物变成了众多斑秃患者的愿望。
就在今年的3月份,国家药监局的一项审批引起了斑秃患者的广泛关注,礼来制药开发的口服JAK*制剂抑**巴瑞替尼,又名艾乐明成为国内首个获批治疗成人重度斑秃的靶向药物。

根据以往的临床试验数据来看,巴瑞替尼可以有效帮助头皮毛发再生,实现约80%以上的头皮毛发覆盖率。
另外还有其他多家药企的适用于重症斑秃的药物还在临床试验开展中。这对于斑秃患者无疑是一个好消息。
参考文献
[1]孟昭群. 养成好习惯,远离头皮毛囊炎[J]. 青春期健康,2022,20(20):14-15.
[2]郝永红. 头皮上的痘痘[J]. 江苏卫生保健,2018(5):45.
[3]陆海涛等主编. 临床皮肤性病学 下 第2版[M]. 长春:吉林科学技术出版社, 2019.03.
[4]张华平主编. 身体健康使用知识手册[M]. 南昌:江西科学技术出版社, 2013.05.
[5]李兴东主编. 脱发 护发 植发[M]. 南京:东南大学出版社, 2019.10.